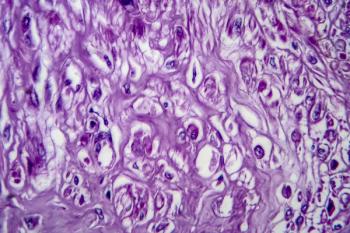

Endometriosis
Latest News
Latest Videos
More News

A study published in the Journal of Ovarian Research examines factors that may cause endometriosis to progress to ovarian cancer.

National awareness months and days span a variety of topics, from celebrated foods (think National Ice Cream Day, National Bagel Day, National Pizza Day) to businesses (free Slurpee at 7-Eleven) to our terrain: health issues. March alone is a national health awareness month for over 10 conditions, one of which is endometriosis.

A survey in the American Journal of Obstetrics & Gynecology revealed that patients with chronic gynecologic pain were twice as likely to use social media to understand or manage their condition than those without pain, at 37.8% vs 19.7% respectively.

Patients with endometriosis are nearly four times as likely to develop rheumatoid arthritis (RA) than those without endometriosis, according to a study in the Journal of Women’s Health.

A study in the Journal of Minimally Invasive Gynecology concluded that, in select pateints with deep infiltrating endometriosis (DIE) whom do not require bowel or ureteral resection, bladder function significantly improves after surgery, both during filling and in voiding urodynamic phases.

While the use of combined oral contraceptives (COCs) among patients with rheumatoid and autoimmune disorders have focused on safety, a narrative review in the Journal of Obstetrics and Gynaecology Research highlighted the efficacy and benefits of these contraceptives in females with rheumatoid arthritis (RA).

A study in the International Journal of Gynecology & Obstetrics found that transperineal ultrasound (TPU) signs of pelvic floor muscle hypertonia are more prevalent in endometriosis patients with chronic constipation than in those without.

There are a number of effective treatments, but a recent study sought to investigate how well oral contraceptives in particular could help reduce symptoms—while preserving sexual quality of life—in women with particularly severe forms of endometriosis.

A case report of infiltrative endometriosis without endometrioma underscores the need to consider endometriosis in the differential for patients with pelvic masses and to recognize possible features that might indicate the diagnosis.

A literature search revealed there is no international agreement on how to characterize or classify endometriosis.

Testing for pelvic floor tenderness during routine pelvic exams for women with chronic pelvic pain or endometriosis may help identify women who have heightened overall pain sensitivity.

Although bacteria are altered in endometriosis, there is no definitive consensus on specific microbiota compositions linked to the disease, according to a review in Human Reproduction Update.

“Studies like ours may open a new venue of treatment for women with chronic pelvic pain, especially when associated with pelvic floor muscle spasm,” said principal investigator Barbara Karp, MD.

Women exposed to pesticides containing trans-nonachlor were 3.38 times more likely to develop endometriosis (P <0.0001), and for PCB 114 the increased risk was 1.83 (P =0.009).

At AAGL's 50th Global Congress on MIGs, Smitha Vilasagar, MD, FACOG, discussed the diagnosis, treatment, and management of endometriosis in children and adolescents.

A systemic review and meta-analysis in the Archives of Gynecology and Obstetrics has found epidemiological evidence that endometriosis and irritable bowel syndrome (IBS) are connected.

The life impact of endometriosis is similar to other chronic disorders, especially for pain, according to a narrative literature review in the International Journal of Internal Medicine.

A study has found that women with a diagnosis of endometriosis have significantly greater depressive symptomatology, sexual distress, and catastrophizing than age-paired healthy women.

An online explorative observational study in the journal Reproductive BioMedicine Online has found that there are no specific dietary adjustments to increase quality of life among Dutch endometriosis patients.
A study published in Frontiers in Endocrinology correlates US women’s multiple chemical exposures to uterine leiomyoma (UL) or uterine fibroids (UF) and endometriosis (EM).

Several dietary supplements and nutrients potentially provide benefits in preventing and treating common gynecological diseases like uterine fibroids (UFs), endometriosis, polycystic ovarian syndrome (PCOS), infertility, menstrual disorders and vaginal infections, according to an article in the journal Nutrients.

A randomized controlled study in Pain Research & Management validates the potential role of antioxidants in managing endometriosis.

Due to the rarity of the disease and its variability in clinical presentation, the condition is hardly recognized by some health care professionals, leading to a delayed diagnosis.

The researchers developed a potential model for using precision medicine to improve pregnancy outcomes.

Women who undergo endometriosis surgery via diagnostic laparoscopy are significantly more likely to require repeat surgery within the first postoperative year, whereas women who have major conservative surgery are significantly less likely to require another surgery within the first year, according to a Canadian study in the American Journal of Obstetrics and Gynecology.







